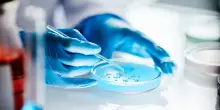

s

Estero
Fungo killer negli ospedali europei, l'alert Ecdc: Italia fra Paesi più colpiti
11-09-2025, 13:15
(Adnkronos) - I dati: "In 10 anni oltre 4mila casi di Candida auris con aumento significativo nell'ultimo anno monitorato, intervenire con urgenza"
CONTINUA A LEGGERE

24

0

0
Adnkronos
08:39
Amici, oggi domenica 21 dicembre: gli ospiti e le anticipazioni
Adnkronos
08:35